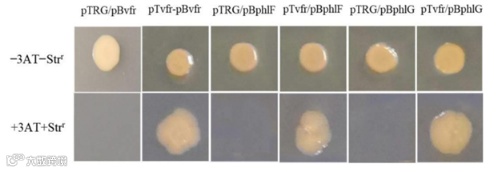

发表单位:扬州大学园艺与植物保护学院
发表日期:2021年5月14日
期 刊:Frontiers in Microbiology(IF:6.064)
2021年5月14日扬州大学园艺与植物保护学院张清霞团队在杂志Frontiers in Microbiology(IF:6.064)发表题为“ChIP-seq Analysis of the Global Regulator Vfr Reveals Novel Insights Into the Biocontrol Agent Pseudomonas protegens FD6”的研究论文。该研究结果表明Vfr通过结合phlF和phlG基因的上游区域,直接调控2,4- DAPG的表达。而且该Vfr结合P. protegens FD6不需要完整的结合共识基序。此外,作者证明了Vfr在该细菌中的表达是自动调节的。这些结果为研究Vfr对P. protegens的调控作用提供了新的思路。爱基百客为该研究提供了ChIP和ChIP-seq的技术支持。



许多假单胞菌蛋白原菌株产生抗生素pyoluteorin (PLT)和2,4-二乙酰间苯三酚(2,4- DAPG),两者都具有抗菌性能。这些代谢物的生物合成通常由多种调节因素控制。毒力因子调节剂(Vfr)是一种多功能的DNA结合调节剂,调节P. protegens FD6中2,4- DAPG的生物合成,但具体调控机制目前尚不清楚。


P. protegens菌株;pUC57- Vfr - 3flag转化P. protegens菌株。





1.Vfr结合位点的鉴定
为确定Vfr-Flag融合蛋白是否在△vfr突变体中成功表达,作者使用Western blot实验进行了验证。结果显示,在△vfr /pBBR- Vfr - 3flag表达的总蛋白中,清晰地观察到一条24.2- kDa的条带,而在阴性对照株vfr/pBBR中未观察到条带。这表明Vfr-Flag融合蛋白成功在体内表达,可以用于进一步的ChIP- seq分析。
ChIP-seq结果峰显示标注了847个基因,约35.51%和64.49%的结合位点分别位于编码序列和启动子区域为进一步阐明已鉴定的Vfr靶基因的分子功能,通过KEGG通路分析进行鉴定。结果显示Vfr结合基因编码的产物具有不同的功能,包括代谢相关(69%)、环境信息处理(16%)、细胞过程(11%)和遗传信息处理(4%)(图1A)。此外,作者通过HOMER分析进一步确定了长度为5bp的Vfr共识基序,该基序已被鉴定为大肠杆菌和铜绿假单胞菌的保守基序(图1B)。

图1 ChIP-seq对Vfr调控进行全基因组分析
作者通过ChIP-seq分析,在phlF、phlG和vfr附近确定了3个Vfr的潜在目标位点。并设计对应引物进行结果验证。ChIP实验结果表明Vfr在体内分别与phlF、phlG、vfr基因上游区域存在结合 (图2)。

图2染色质免疫沉淀聚合酶链反应分析
2.推定Vfr调控的表达基因
为了确定ChIP-seq所鉴定靶基因的调控是否依赖于Vfr,作者通过qPCR检测了野生型和Vfr突变体中代表性靶基因的表达。结果显示,与野生型相比在△vfr突变株中大部分目的基因表达量明显降低,但存在5个基因表达量增加(图3)。表达下调的基因包括编码VI型分泌系统成分的tssJ和tssA基因以及参与2,4-DAPG生物合成和调控的phlF、phlG基因等。

图3 Vfr调控基因的qPCR分析
3.用细菌单杂交报告系统测定DNA-Vfr特异性相互作用
细菌单杂交报告基因系统是一种体外检测蛋白质- DNA相互作用的有效方法。作者通过实验证实了Vfr蛋白可以与自身基因启动子区域相结合,此结果与前人在铜绿假单胞菌中研究结果一致,进一步说明Vfr蛋白具有自调控功能(图4)。
作者用特异性引物扩增phlF和phlG的上游区域,插入报告载体pBXcmT。将vfr基因克隆到pTRG中。如图4所示,pTvfr/pBphlF或pTvfr/pBphlG菌株与阳性对照一样能在含有3AT和Strr的培养基上正常生长,而pTRG/pBphlF或pTRG/pBphlG菌株无法生长。这些结果表明,Vfr特异性地结合phlF和phlG上游区域。
图4使用细菌单杂交报告系统确定DNA结合特异性
4. Vfr在体外与各种靶点相互作用
作者通过EMSA实验鉴定vfr、phlF和phlG上游区域的Vfr结合区域,结果显示,在0.5 μg和2 μg 的Vfr存在下,vfr,phlG和phlF的上游片段迁移率出现部分延迟或完全延迟,这表明与这些片段相对应的区域含有Vfr结合基序。此外,当未标记的探针作为竞争抑制剂加入到反应体系中时,可以观察到Vfr在Vfr、phlG和phlF基因上游区域呈现竞争性抑制(图5A C)。为了进一步定位Vfr结合位点,作者合成了vfr、phlF和phlG上游区域的三个较小(25- bp)片段,并观察到这些片段存在时的凝胶位移带,结果表明,三种探针均具有一致的Vfr结合位点,这些位点对于Vfr蛋白结合到vfr、phlF和phlG上游区域至关重要(图5D)。

图5 Vfr特异性结合于Vfr、phlF和phlG上游区域
ChIP-seq分析结果表明,TCACA基序高度保守,潜在的Vfr共识序列位于vfr (TCACA)、phlF (TTACG)和phlG (ACACA)的上游区域。为了验证该分析结果,作者分别将TCACA、TTACG和ACACA序列突变为TTTTT、TATTT和ATTTT,使用以上3种突变探针进行EMSA(图6a)。结果所示,Vfr与vfr,phlF和phlG探针结合,并与未标记的野生型探针存在竞争性结合,而突变探针竞争无效。因此作者将Vfr蛋白在上述3种基因中结合位点均定位在了一个长度为25bp的区域,此区域中存在5bp共识序列。综上所述,这些结果表明Vfr特异性地与ChIP-seq识别的两个新的结合位点相互作用,而不需要之前已知的Vfr共识motif。

图6 EMSA检测证实了Vfr与vfr、phlF和phlG衍生物探针的结合
小结
在本研究中,作者利用flag标记的Vfr的染色质免疫沉淀和核苷酸测序分析,确定了P. protegens FD6中847个可能的Vfr结合位点。经核苷酸序列比对预测的P. protegens Vfr结合位点为TCACA。qPCR数据显示Vfr正向调控phlF和phlG的表达,并对这些基因的表达进行了详细的注释。纯化的重组蛋白Vfr结合在phlF和phlG上游区域约240 bp的片段,该区域有推定的Vfr一致序列。利用电泳迁移率转移试验,作者定位了Vfr与包含部分Vfr结合区域的25 bp片段的结合。并通过分别突变phlF和phlG的TACG和CACA序列,证实了Vfr结合。
综上所述,作者的结果表明,Vfr通过结合phlF和phlG基因的上游区域,直接调控2,4-DAPG操纵子的表达。然而,与其他Vfr靶向基因不同,Vfr结合P. protegens FD6不需要完整的结合共识基序。此外,作者证明了Vfr在该细菌中的表达是自动调节的。这些结果为研究Vfr对P. protegens的调控作用提供了新的思路。
往期推荐:


点击下方↓↓↓“阅读原文”下载文献


